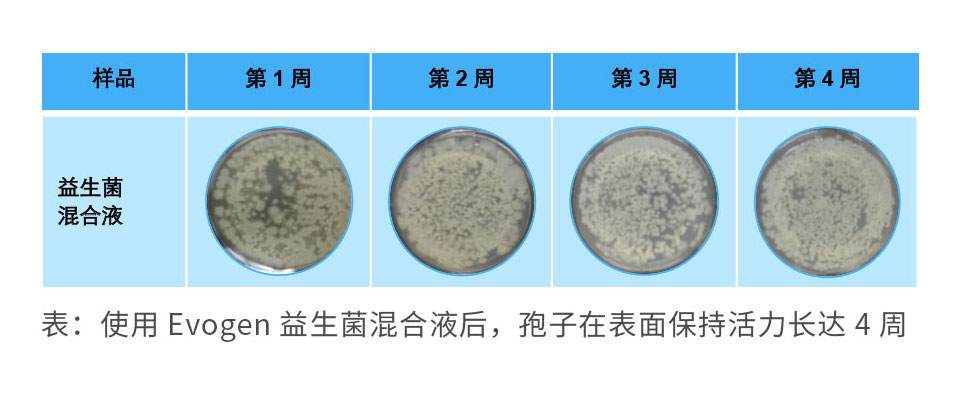
041804

“香臭”还是“除臭”,这是个问题
车门是个分界点,推开车门,你是父亲、是儿子、是老公...是柴米油盐,却唯独不是你自己。而关上车门,抽根烟,发个呆,这个小小的世界就只属于你,以及……可怕的异味!
“汽车异味”一直是汽车安全问题中最容易被忽视的;它们虽然看不见摸不着,但所散播出的甲醛、TVOC、细菌和霉菌等有害物质,经过日积月累后将对人体健康造成严重的负面影响,甚至带来致癌隐患...
对此很多“老司机”总会选择欲盖弥彰,用各种香水、清新剂来掩盖,结果往往只是过了鼻子这一关,治标不治本;有时还因为多种气味的混杂而产生更多有害化学成分...
今天,几位”除味达人“找到了禾大智囊团,为解决汽车的异味难题献计献策,希望能觅得真正的“隐藏的除味王者”,让我们一起来看看他们的问题吧!
1号除味达人:
“新车车内总有一股浓烈的塑料和橡胶味,坐久了甚至想吐...我特意在网上查了一些方法,比如开窗通风、放置果蔬皮和活性炭、食醋除味,可是见效很慢不彻底...我是不是该买点空气清新剂喷喷呢?”
2号除味达人:
楼上,我跟你说空气清新剂没用的。我家里有宝宝和老人,也很关注车内异味问题,之前就会用一些车载香水和空气清新喷雾,但总会有香味和异味混杂出的其他古怪味道出现...想问问禾大老师有什么天然绿色温和的除味产品推荐吗?
- 禾大智囊团 -
“确实,大部分的空气清新剂和香氛并不起到除味的作用,虽然短时间内可以立马感受到异味的减淡,但只是以味盖味,长期使用不够绿色环保,还会挥发出其他有害化学物质,对人体造成危害...”你们两个的问题很相似,这里给你们推荐一款“绿色环保的气味中和剂”~
↓
「爱与和平节能使者——Zinador™35L」
作为85%生物基的气味中和剂,Zinador™35L具有优异的温和度及宽广pH稳定性。有效去除多种臭味的同时不产生其他表面残留物,拥有食品级防腐剂;与其他锌基除味剂相比自身几乎无气味、配制更简单,无需额外添加乳化剂等;100%溶于水,可与其他香精并用。
【实战演练——异味中和】
Zinador™35L可以中和多种不同类型的异味,且与其他锌基除味剂相比,除味性能更为优异。
1.在针对去除氨味的性能实验
根据下图气相色谱分析表明,在锌含量相同的情况下,Zinador™35L与竞品锌(约0.03%)相比,对于氨味的去除效果更显著。

2.针对减少鱼腥味的性能实验
根据下图气相色谱分析表明,在锌含量相同(约0.03%)的情况下,Zinador™35L再次展现出了去除鱼腥味的优异能力。

【关于Zinador™35L的锦囊妙用】
①85%生物基产品,拥有优异的pH稳定性,能够去除多种臭味(可用于配置出绿色温和的气味中和剂)
②100%溶于水,可与多种香精并用,无需添加额外乳化剂(可提供更加灵活简易的配方可能,节省成本)
③与高盐和高活性物含量表面活性剂配方的相容性良好(可在多种洗涤配方中保持透明,使用后不会留下印记)
3号除味达人:
“上面二位的方法我之前都试过,最后还是选择到外面找专业的洗车店帮忙做除味,放心也省心;但我是个老烟民,平时就爱在车里抽烟,所以车内的清新总是持续不了多久...有没有什么自己在家就能搞定,持久还安全无害的除味剂呢?”
- 禾大智囊团 -
“首先要恭喜你,对于除味的觉悟已经进阶至3.0了,不过针对人为异味,想要做到长久的抑制确实不是一件易事,对此禾大老师也将拿出一件新型除味法宝来助你一臂之力~”
这里,推荐你一款“益生菌抑味混合液”
↓
「异味时效管理大师——Evogen™ ON 50x」
Evogen™ ON 50x是一种创新型益生菌混合液,它可在异味产生前,先行分解异味来源的污垢,防止异味形成;且在对抗异味过程中,能够持续保持活性,长效地减少异味生成。
【实战演练1——除味能力】
Evogen™ ON 50x的除味能力主要体现在能够在各类微生物出现腐败前就将其代谢中和掉,将异味从源头瓦解。

上图中显示,随着时间的推移,Evogen™ ON 50x不仅能够代谢形成恶臭的污垢,还能自行代谢当前的恶臭分子,降低异味产生的浓度。
【实战演练2——持久抑味能力】
Evogen™ ON 50x益生菌混合物可提供长效抗污保护其菌株可保持活性长达4周,防止污垢积存导致的异味再发酵。
同时为了评估Evogen™ ON 50x能否随着时间的推移,仍具备气味中和的能力,将由6人组成的气味测试小组,分别对不同气味进行不同时间段的气味“盲”测;

根据0-6分评分系统显示,Evogen™ ON 50x在48小时内,对于各类异味的中和仍然有效且呈现递减的趋势。
【关于Evogen™ ON 50x的锦囊妙用】
①主要成分为可在肠道中存活的益生菌,拥有绝对安全绿色的来源(可用于宠物及婴儿类的清洁护理产品中,提供创新型的除味技术与可信赖的产品背书)
②分解产生异味的污垢,可从源头将异味瓦解(可与多种表面活性剂复配,兼容性好)
③使用过程中可持续保持活性,以达到长期的异味抑制中和效果(为除味类产品带来持久有效的差异化性能,提升产品的性价比)